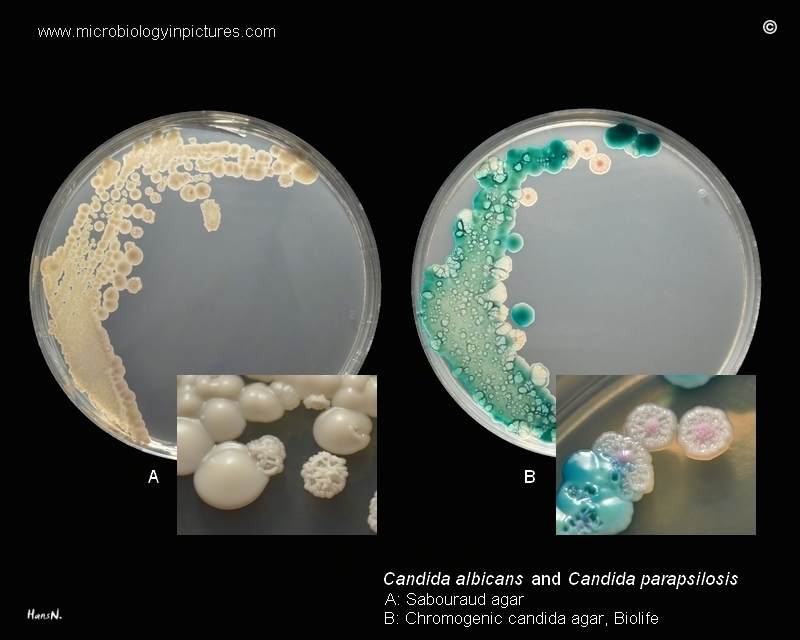

Colonies of Candida albicans and C.parapsilosis on Sabouraud agar and Chromogenic candida agar (Biolife). Cultivation
48 hours at 37°C + additional 24 hours at room temperature.
Result:
Candida albicans green colonies
Candida parapsilosis pink colonies
